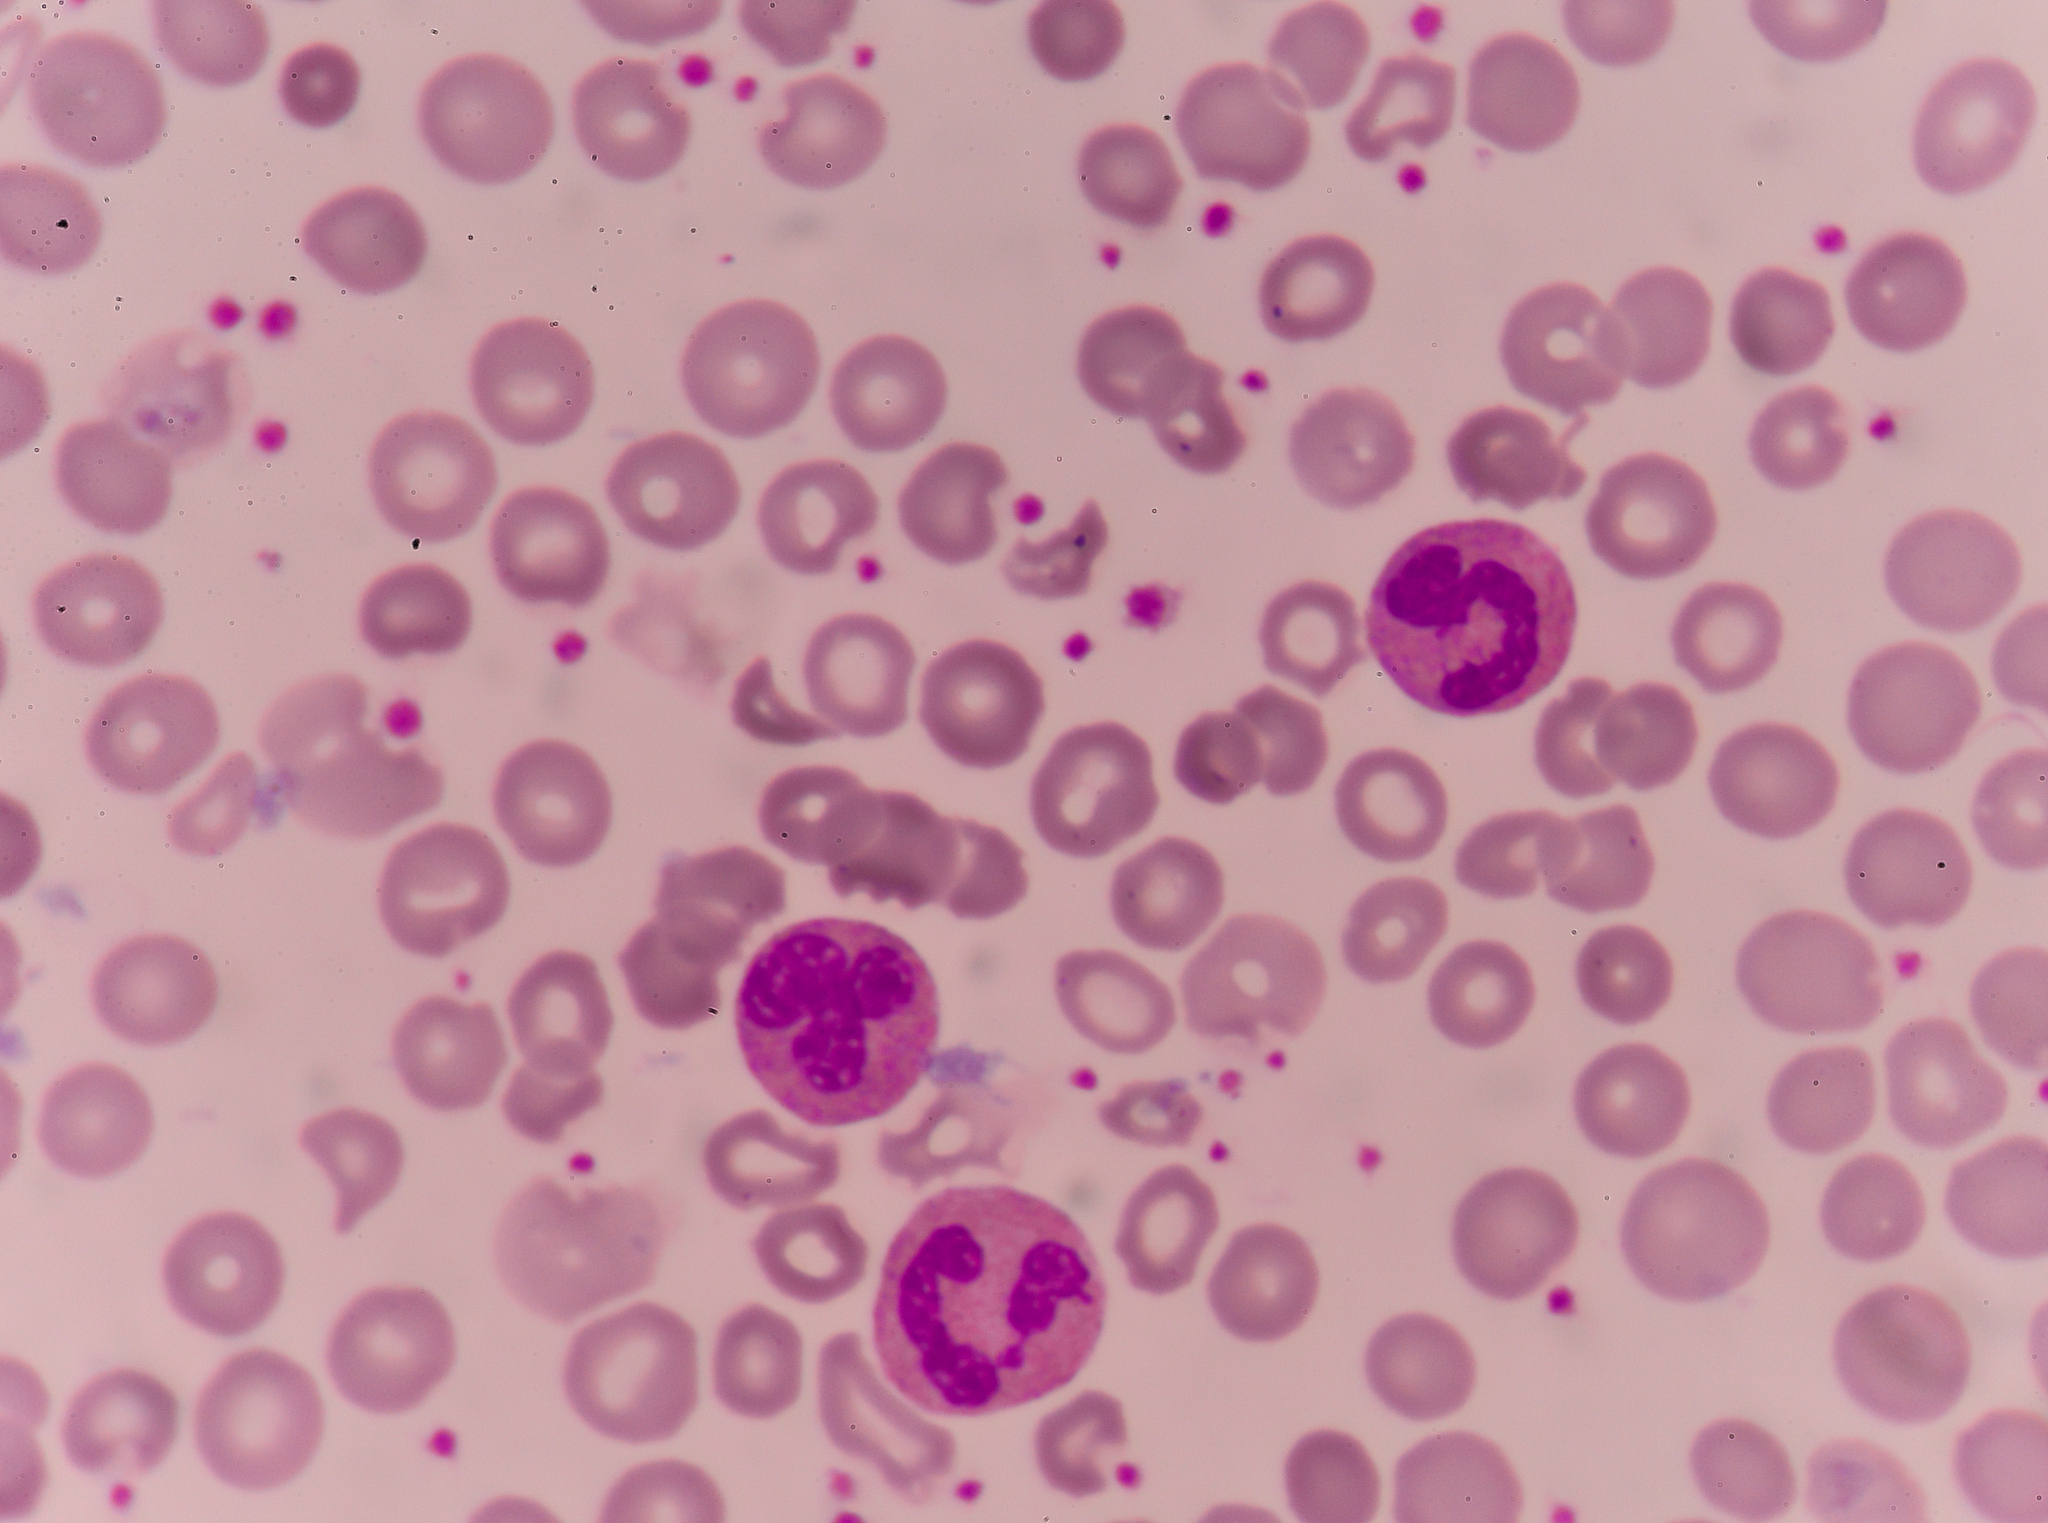
疱疹性咽颊炎血常规异常解读：红细胞压积低、血小板分布宽度高、白细胞计数低等意味着什么？

疱疹性咽颊炎血常规异常解读:红细胞压积低、血小板分布宽度高、白细胞计数低等意味着什么?
根据血常规结果,孩子可能存在以下情况:\n\n1. 红细胞压积值低:红细胞压积值低表示红细胞数量较少,可能与贫血有关,但需要进一步检查确定贫血的原因。\n\n2. 平均红细胞体积值低:平均红细胞体积值低表示红细胞大小较小,可能与某些营养不良、缺铁性贫血等有关。\n\n3. 红细胞宽度-SD值低:红细胞宽度-SD值低表示红细胞的大小分布较为均匀,一般情况下没有特殊意义。\n\n4. 血小板分布宽度值高:血小板分布宽度值高可能表示血小板数量的变化较大,可能与炎症、感染等有关。\n\n5. 白细胞计数值低:白细胞计数值低表示白细胞数量较少,可能与免疫系统异常、感染等有关。\n\n6. 中性粒细胞计数值低:中性粒细胞计数值低表示中性粒细胞数量较少,可能与感染、免疫系统异常等有关。\n\n7. 淋巴细胞百分比高:淋巴细胞百分比高表示淋巴细胞数量相对较多,可能是免疫系统对病原体的反应。\n\n8. 中性细胞百分比低:中性细胞百分比低表示中性细胞数量相对较少,可能与感染、炎症等有关。\n\n需要结合孩子的具体症状和体征,结合其他相关检查结果进行综合分析,最好由专业医生进行评估和诊断。
原文地址: https://www.cveoy.top/t/topic/pTO4 著作权归作者所有。请勿转载和采集!